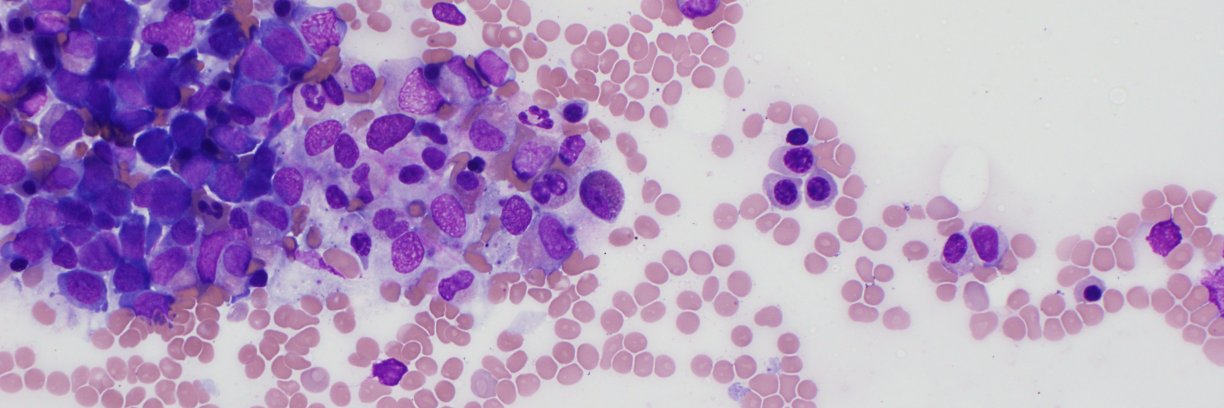
beth margolskee banner

beth margolskee
869 posts

beth margolskee
@bethmcm
MD, MPH. Hematopathology @ CHOP/HUP. Lab director. R amateur. Workforce resilience for clinical labs. Opinions/views are my own. she/her/hers
Beigetreten Mart 2009
503 Folgt1.2K Follower

@SibaElHussein I moved from an adult to a pediatric hemepath practice. I think the biggest clue that it’s B-ALL is that it’s a child. It really takes a LOT for us to begin thinking about a mature B cell process in our kiddos- particularly in marrow/PB.
English

This pediatric case ended up harboring KMT2A rearrangement, supportive of the diagnosis of B-AL
Some take home messages:
🩸TdT negativity, which is uncommon in B-ALL overall, is relatively frequent in KMT2A-rearranged B-ALL, as is CD10 negativity
#Hemepath #Leusm #MedTwitter
English

@ThePAWearsPrada Still can’t believe how our paths crossed, Olivia!
English

I am honored to have been invited to the People of Pathology podcast, where Dennis and I discuss how students can find more shadowing opportunities and what to do when they shadow!
People of Pathology Podcast@peopleofpath
How can prospective PA students get shadowing opportunities? Olivia Josephsen @ThePAWearsPrada and I give you practical tips in this new episode. Listen here: Apple: lnkd.in/gZq5uut Spotify: lnkd.in/gHqNMcb #pathologistsassistants #PathAShadow #pathology
English


@matthewoberley Apparently at SH in Istanbul a 14 yo was presented…but essentially same thing
English

@PedsHemeDoc This! I wish all pediatricians took this approach!
English

@bethmcm OMG, I cannot tell you how many poor parents I’ve talked down off a ledge who thought their kid had CLL because the lab reported smudge cells on a smear and they googled it 😭😭😭
English

Happy to have our Phlebotomy training program featured in CAP Today. With short-staffing and the unique needs of peds phlebotomy, we asked if we could "Grow our own" phlebotomists on par with to traditional hires. More here: captodayonline.com/phlebotomy-pro…
English


The first sign a patient has #spherocytosis is that feeling that you need to move the PB smear slide farther left or right in order to find cells with good central pallor. #hemepath

English

Update from Philadelphia: meet “chuck from Mt Airy. tinyurl.com/2z7bhbhr
English

It is official…
Couldn’t be more excited about the next chapter in my career working with the amazing @PennMedicine & @PennPathLabMed team!

English
beth margolskee retweetet

New Clinical Chemistry podcast: Assessing the Accuracy and Clinical Utility of ChatGPT in Laboratory Medicine buff.ly/3qelVd4
English

@MArnold_PedPath Sad to hear this news. She seemed like a lovely person and a great leader
English

Working in #PediPath and knowing Dr. Dishop’s contributions to our field, news of her passing is heartbreaking

English
beth margolskee retweetet

Penn is recruiting for a Thoracic/Cardiothoracic Pathologist for a 7/1/24 start. Come join our growing team. @lendeschwartz @emma_furth @aakasharmand @cindy_mcgrathmd @rashmitondon @KStashMD @DrNetto @PennPathLabMed
apply.interfolio.com/126730
English




